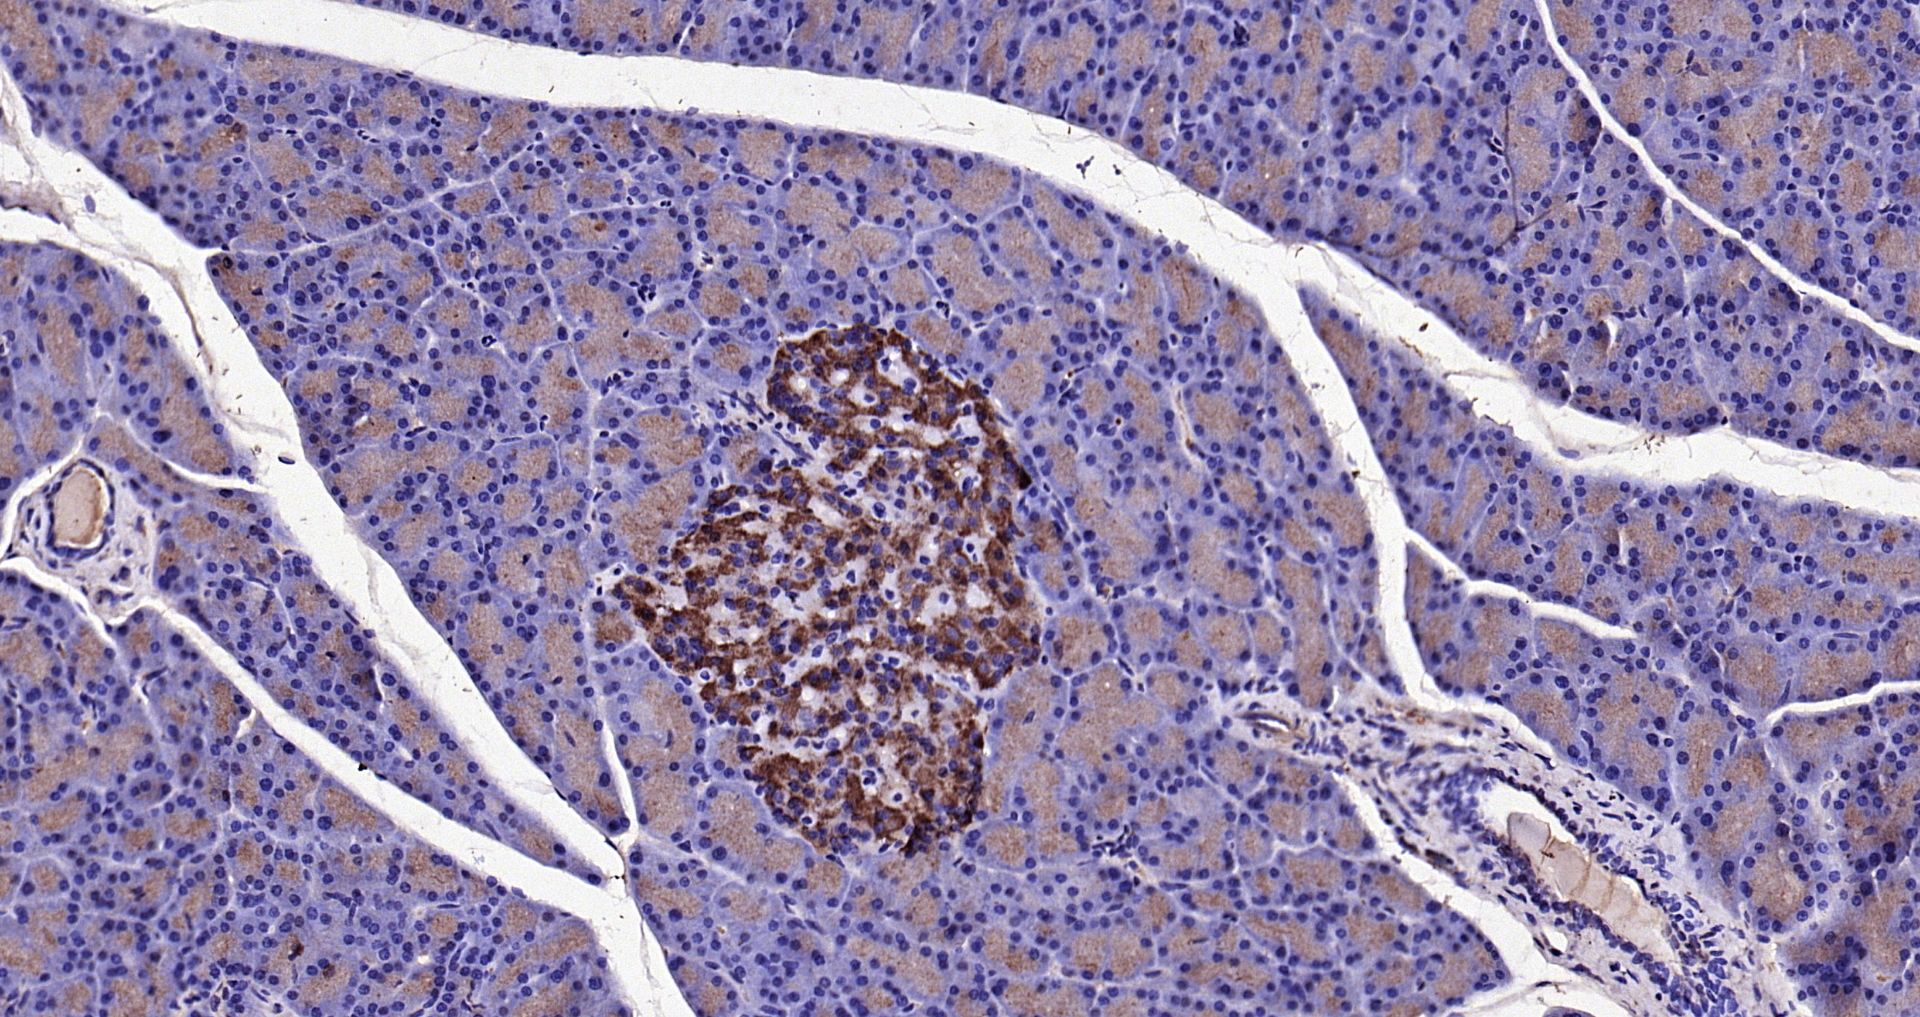

Formalin-fixed and rat kidney tissue labeled with Anti-KLK1 Polyclonal Antibody (bs-1963R), Unconjugated at 1:200 followed by conjugation to the secondary antibody and DAB staining
KLK1 Polyclonal Antibody
BS-1963R
ApplicationsFlow Cytometry, ImmunoFluorescence, ELISA, ImmunoCytoChemistry, ImmunoHistoChemistry, ImmunoHistoChemistry Frozen, ImmunoHistoChemistry Paraffin
Product group Antibodies
ReactivityCanine, Equine, Human, Mouse, Porcine, Rabbit, Rat
TargetKLK1
Overview
- SupplierBioss
- Product NameKLK1 Polyclonal Antibody
- Delivery Days Customer16
- ApplicationsFlow Cytometry, ImmunoFluorescence, ELISA, ImmunoCytoChemistry, ImmunoHistoChemistry, ImmunoHistoChemistry Frozen, ImmunoHistoChemistry Paraffin
- Applications SupplierELISA(1:500-1000), FCM(1:20-100), IHC-P(1:200-400), IHC-F(1:100-500), IF(IHC-P)(1:50-200), IF(IHC-F)(1:50-200), IF(ICC)(1:50-200)
- CertificationResearch Use Only
- ClonalityPolyclonal
- Concentration1 ug/ul
- ConjugateUnconjugated
- Gene ID3816
- Target nameKLK1
- Target descriptionkallikrein 1
- Target synonymsKLKR, Klk6, hK1, kallikrein-1, glandular kallikrein 1, kallikrein 1, renal/pancreas/salivary, kallikrein serine protease 1, kidney/pancreas/salivary gland kallikrein, tissue kallikrein
- HostRabbit
- IsotypeIgG
- Protein IDP06870
- Protein NameKallikrein-1
- ReactivityCanine, Equine, Human, Mouse, Porcine, Rabbit, Rat
- Storage Instruction-20°C
- UNSPSC41116161